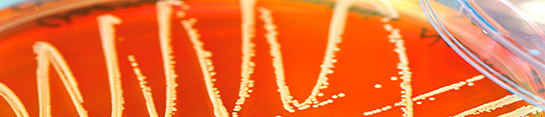

Le Laboratoire de diagnostic de l’Institut universitaire de microbiologie offre un large panel d’analyses pour l’identification des agents de maladies infectieuses. De plus, il a développé des techniques de culture et des méthodes de diagnostic moléculaire pour la détection et l’identification de pathogènes microbiens communs et plus rares.
Statistiques de sensibilité des principales espèces bactériennes en 2025
Les tableaux de ce document résument les statistiques de sensibilité aux antibiotiques des souches cliniques isolées au laboratoire de bactériologie médicale. Cette statistique n'inclut pas les souches issues de prélèvements de surveillance et ne différencie pas, à ce stade, les souches nosocomiales des souches communautaires.
Laboratoire de l'Institut de microbiologie
Lundi-vendredi: 8h-17h
Samedi: 8h-14h
Dimanche et jours fériés: 10h-14h
Service d'urgence de 7h à 22h sur appel au 021 314 41 07